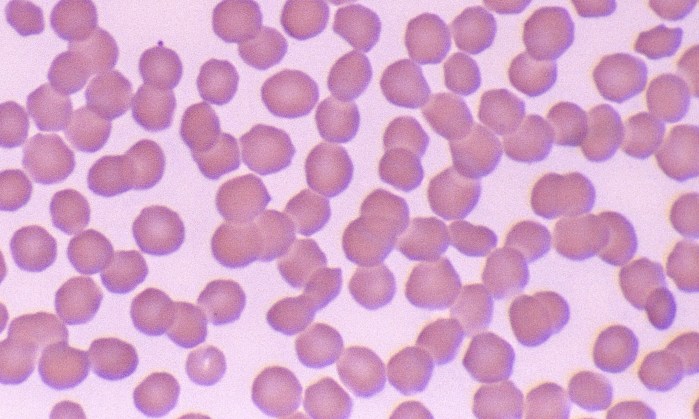
Normal Sheep 3

Normal Sheep Erythrocytes

Morphology: small red blood cells with mild anisocytosis and little to no central pallor.
Lifespan: 150 days
Other features: slight poikilocytosis may be normal. Crenation of red blood cells with sharp-pointed margins is a common artifact. Polychromatophils, basophilic stippling, nucleated red blood cells, and Howell-Jolly bodies are common in response to anemia.